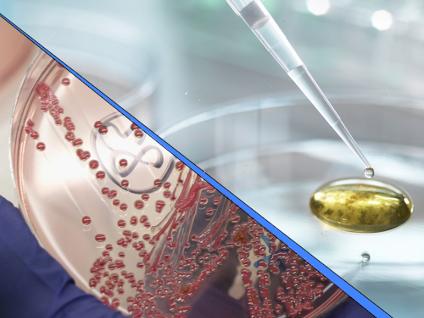

Campus Centres, Institutes, and Groups
The University of Guelph’s research centres, institutes, and groups bring together experts from diverse fields to tackle complex global challenges. These collaborative hubs drive innovation in areas like food, health, environment, and society. Explore the full list below to see how our research community is working to Improve Life.
Centres and Institutes
The University of Guelph's Policy and Procedures on Research Centres and Institutes, and Scholarly Chairs outlines the process for establishing a centre or institute, governance expectations and reporting requirements. The official version of this policy is housed with the University Secretariat.

Aquaculture Centre

Arrell Food Institute

Bench to Bedside Institute for Translational Health Research and Innovation

Biodiversity Institute for Conservation Synthesis (BICS)

Campbell Centre for the Study of Animal Welfare

Canada Cyber Foundry (CCF)

Canada India Research Centre for Learning and Engagement (CIRCLE)
Canadian Research Institute for Food Safety (CRIFS)

Centre for Advancing Responsible and Ethical Artificial Intelligence (CARE-AI)

Centre for Agricultural Renewable Energy and Sustainability (CARES)

Centre for Biodiversity Genomics

Centre for Cardiovascular Investigations (CCVI)

Centre for Nutrition Modelling

Centre for Public Health and Zoonoses

Centre for Scottish Studies

Centre for the Genetic Improvement of Livestock

Community Engaged Scholarship Institute (CESI)

Controlled Environment Systems Research Facility

Dairy At Guelph

Electrochemical Technology Centre

Equine Guelph

Gosling Research Institute for Plant Preservation (GRIPP)

Guelph Food Innovation Centre (GFIC)

Guelph Institute for Development Studies (GIDS)

Guelph Institute for Environmental Research (GIER)

Guelph Turfgrass Institute (GTI)

Honey Bee Research Centre

Institute for Comparative Cancer Investigation (ICCI)

Institute for Lifestyle Integration of Food and Exercise (Institute for LIFE)

Institute for Sustainable Commerce at Guelph

International Institute for Critical Studies in Improvisation (IICSI)

John F. Wood Centre for Business and Student Enterprise

Live Work Well Research Centre

Marketing Analytics Centre

Morwick G360 Groundwater Research Institute

One Health Institute

Ontario Rural Wastewater Centre

Re-Vision: The Centre for Art and Social Justice

Share Hierarchical Academic Research Computing Network (SHARCNET)
Groups

Arboretum Gene Bank

Bioproducts Discovery and Development Centre

Canadian Wildlife Health Cooperative (CWHC)

Guelph Wastewater Facility (GWF)

Guelph-Waterloo Centre for Graduate Work in Chemistry and Biochemistry (GWC2)

Hagen Aqualab

Human Nutraceutical Research Unit

Landscape Architecture Community Outreach Centre

Health Sciences Centre

Maplewoods Centre for Family Therapy and Child Psychology

Nuclear Magnetic Resonance Centre

Organization and Management Solutions

Physical Science and Engineering Education Research Centre (PSEER)

Robotics Institute @ Guelph

Soils at Guelph
